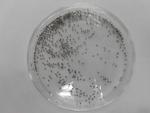

2020学校日記
4月9日(金) 創立記念式
今朝は学校の創立記念式からスタートです。明治38年の4月11日に開校した南吉田小学校は今年116歳を迎えます。昔の学校の写真を見て「古いな~」と驚く子どもたちです。長い歴史をもつ本校には大勢の卒業生がいて今でも母校に関心を寄せてくださっています。後輩の面倒をみてくださる伝統は今も子どもたちに受け継がれており、今日も登校班の班長さんが下級生のお世話をしっかりと見てくれていました。6組では上級生が下級生の手を引いて「こっちだよ」といいながらクラスにあいさつに出かけていました。素敵な光景です。
手をつないだり、遊具で遊んだりしたあとはしっかり手洗いです。
116年目の学校生活のスタートです。
4月8日(木) 学級学年開き
新年度2日目。少し緊張した面持ちで集団登校してくる子どもたちです。新しく班長になった子は、安全に気をつけながら下学年の子を引率してきてくれました。
新しいクラスのスタートです。自己紹介で盛り上がり、新しい教科書を渡されてワクワクしながら開く子どもたちです。1年生はロッカーや靴箱の確認など新しい学校生活の約束に一つずつ慣れていきます。
6年生は学年集会を開いて最高学年としての自覚を促していました。
新しいことにチャレンジしてできることを増やしていきましょう。
4月7日(水) 入学式
116人の新入生を迎えて入学式を行いました。今年もコロナの影響で来賓の皆様を招待できず、保護者の方1名限定という制限のある中での式でしたが、新1年生は最後まで立派な態度で参加できました。登校を見守ってくださった皆様、メッセージをくださった皆様、祝電をいただいた幼稚園・保育園の皆様ありがとうございました。明日から南吉田小学校の児童として元気に登校してください!
4月7日(水) 着任式・始業式
着任式で16人の教職員を迎えました。初めて会う職員に子どもたちは興味津々です。久しぶりに全校が集まっての式でしたが、子どもたちはしっかりとした態度で臨めました。始業式では「何にでもチャレンジしよう」「お友達を大切にしよう」(いじめのない学校にしよう)「健康と安全に気をつけよう」という話をしました。まだまだウイズコロナの生活は続きますが、新しい学年でも「できない」ことを「できる」に変えていく力を発揮してほしいと思います。保護者・地域の皆様今年度もどうぞよろしくお願いいたします。
4月6日(火) 新年度準備
新6年生が7日の始業式・入学式に向けて新年度準備をしました。体育館で説明を聞いた後、1年生の教室環境を整備する係、入学式会場をつくる係、教科書をセットする係などに分かれて最高額年としての初めての仕事に取り組みました。学校全体のために張り切って仕事をしてくれた6年生ありがとうございました。
3月26日(金) 修了式 離退任式
令和2年度の修了式を行いました。児童代表の5年生が「今年はコロナでいつもと違ったけれど、体験学習の行き先を自分たちで考えたり、行程を調べて決めたりしました。」と発表してくれました。普段とは違う1年でしたが、終わってみれば工夫してアイデアを出し合い、自分で考えて新しいことを生み出す経験を重ねたように思います。「できないをできるに変える力」が育ったのではないでしょうか。できるようになったことを自信に変えて前に進んでほしいと思います。今年から「あゆみ」とは別に「自分づくりパスポート」という子ども自身が成長の足跡を振り返るファイルを積み重ねていきます。
3月で離任・退任する教職員の離退任式を行いました。今年もテレビ放送での式となりましたがお別れする先生たちのメッセージを真剣に聞く子どもたちでした。最後は満開の桜の木の下で広報誌に載せる写真撮影です。育友会の皆様ありがとうございました。
3月24日(水) 白衣補修
育友会の保健委員会とボランティアの皆さんで給食白衣の点検と補修をしてくださいました。本校では白衣は1年間貸与して年度末に返却するシステムをとっていますが、1年間使った白衣は少々くたびれ気味で戻ってきます。そんな白衣を次の年に気持ちよく使えるように補修しています。この作業は例年かなりの労力を必要とすることから新1年生からは個人で購入するシステムに移行します。みなさんご協力に感謝します。
3月23日(火) 学校をよりよくする提案
6年生が卒業し最上級生となった5年生の代表が国語で学習した「学校をよりよくする提案」のプレゼンをしてくれました。教室にZOOMで中継されているため緊張した面持ちで校長室に入ってきた4人の子どもたち。順番に資料を見せながら提案していきます。「ペア学年を同じフロアで勉強できるようにしてください」「全校の子どもたちが交流できるようにしてほしい「校庭だけでなく体育館も休み時間に開放してほしい」「いじめをなくすアンケートを取りたい」など自分たちで考えて、アンケートを取ったり他の学校の様子を調べたりして、図表にまとめ説得力のある提案です。中にはロイロノートでプレゼン資料を作成する子も。自分たちの力で学校を変えていこうとする子どもたちの力強さと、主体的に考える力の育ちを感じるプレゼンでした。来年度実現できように子どもたちと一緒に考えていきます。
3月19日(金) 卒業式
122人の子どもたちが卒業しました。コロナの影響で様々な制約のある中での式となりましたが、立派な姿を見せて巣立っていきました。南吉田小学校の職員はいつまでも皆さんの応援団としてエールを送り続けます。素敵な未来を切り拓いてください。保護者の皆様には6年間学校の教育活動にご協力いただきありがとうございました。
3月18日(木) 6年生を送る会
6年生と在校生が別れを惜しむ会を行いました。各学年の児童が6年生に感謝の言葉を伝え、6年生がそれに応える形で在校生へのビデオメッセージを流しました。最後には廊下やスロープ、階段に並んだ在校生の前を6年生が歩いて別れを惜しみました。カウントダウンカレンダーもいよいよ残り1枚です。
3月17日(水) 最後の給食
令和2年度最後の給食は南吉田特別メニューでした。鶏肉のパン粉焼きはオーブンで調理したジューシーな食感で大好評でした。1年間安全でおいしい給食を提供してくれた藤給食センターの皆さんありがとうございました。
3月16日(火) ペア学年集会
6年生と1年生が最後のペア学年集会をしました。一緒に玉入れをしたり、じゃんけん列車をしたり・・。5時間目には5年生と3年生が大縄大会をしました。南風が吹いて気温が上がる中で半袖の子もちらほら。みんな笑顔の一時です。
3月15日(月) 6年生お別れ集会
卒業まで残り5日となった6年生がお別れ集会=ロッククライミングカップを行いました。リレーをしたり玉入れをしたり、鬼ごっこをしたり思い切り体を動かして友だちとの最後の日々を楽しみました。下校する1年生が「6年生はすごいな」と応援していました。
3月12日(金) 6年生ありがとう集会
卒業まであと5日となった6年生に、ありがとうのメッセージを伝える集会を放送で行いました。「6年生の好きな遊びは?」「6年生に人気の給食メニューは?」など6年生クイズが出題されたあと、サプライズ企画で1年生から5年生が撮ったビデオメッセージが流されました。6年生は目をウルウルさせながらメッセージに見入っていました。残された日はわずかですが引き続き優しくて、頼りになる最上級生でいてください。
3月11日(木) 東日本大震災から10年
東日本大震災から10年の月日が流れました。中学年より下の子どもたちは産まれる前のことですし高学年の子どもたちでもほとんど記憶はないでしょう。けれども災害の記憶はしっかり伝承していかなくてはいけません。防災教育の専門家がこんなことを言っています。「これまで学校内にいる時間帯で子どもたちを守ろう、避難させようとしてきましたが、学校外で災害に遭遇したときに、どう行動するか判断できるようにならなければ自分の命を守ることはできません」(日本教育新聞2021.3.8)学校でも自分で考えて避難行動できる子どもを育てていきたいです。
3月10日(水) 学習の振り返り
「いいこといっぱい1年生」というタイトルのファイルをつくっています。これまで書きためた朝顔の観察記録や運動会の振り返り、遠足の見つけたよカードなど1年間の学びや生活の足跡がわかる記録を綴ることで成長を振り返っています。1年生はたくさんのことができるようになって、間もなく入学する新1年生を迎える準備を始めています。
3月8日(月) 卒業に向けて
卒業生を送り出す企画があちこちで進行中です。3階の階段には大きなカウントダウンカレンダーが出現しました。体育館には各学年で制作した卒業を祝う作品が掲示されました。そして校内のあちこちには6年生ありがとうのメッセージが貼られています。卒業式の練習も始まり、6年生は旅立ちに向けていよいよ滑走路を走り出しました。立派に巣立ってくれることでしょう。
3月5日(金) お絵かき集会
今年度最後の児童集会はリクエストの多かった「お絵かき集会」でした。今日のお題は「担任の先生」です。一人4秒のリレー方式で絵をかいていきます。どんな絵になるのかと思いきや、担任の特徴をとらえてなかなかのできばえのクラスもあった一方、「え、これが○○先生?」と??がつくクラスも。かき終えた絵は放送室に集められ全校にお披露目です。朝から大爆笑の集会でした。集会委員のみなさんコロナでも楽しい集会をありがとうございました。
3月4日(木) お楽しみ給食(6年生)
卒業を控えた6年生のためにお楽しみ給食を行いました。ミニ揚げパン、野菜のスープ煮、果物に6年生は特製ミートローフを追加しての献立です。給食室からの心のこもったプレゼントに子どもたちは大満足でした。
3月3日(水) 桃の節句
今日はひな祭り。学校の玄関に飾られた雛人形も心なしか晴れがましい表情に見えます。
職員室まえの廊下に市の児童書写展に出品した子どもの作品が展示されています。とても立派な作品に仕上がっています。読書感想画コンクールに出品した児童、学校の図書館で年間を通して多くの本を借りた児童とあわせて表彰しました。

3月2日(火) JICA青年海外協力隊
6年生が青年海外協力隊でバングラデシュとスリランカに派遣されていた先生(本校職員)をゲストに招き、国際協力や国際交流の実際について学びを深めています。スライドで現地の生活や学校の様子を見たあとで民族衣装の試着タイムも。素敵な民族衣装を着て楽しそうな子どもたちでした。将来国際協力に携わる仕事やボランティアとして活躍してくれる子がでてくることを期待します。
3月1日(月) 春の火災予防運動
3月1日(月)~7日(日)は春の全国火災予防運動期間です。この一環で、横浜橋通商店街に本校児童の火災予防ポスターが掲示されます。(冬休みにポスター募集に応募した全員)また本校児童が録音した多言語による火災予防アナウンスも同時に流れます。横浜橋通商店街にお立ち寄りの際はポスターとアナウンスにご注目ください。
そして今日は南消防署長様が賞に選ばれたポスターを描いた児童の表彰に来てくださいました。商店街の理事長賞に輝いた児童の作品は中村小、石川小の児童作品とともにたて2m×よこ3mの横断幕に印刷されるそうです。ポスターに応募してくれた子どもたちにはタオルが参加賞として届いています。
2月25日(木) クラブ発表週間
今週はクラブ発表週間です。各クラブが作品を展示したりVTRで活動の様子を紹介したりしています。コロナの影響で今年は回数が減ってしまいましたが子どもたちは楽しく活動していました。
2月22日(月) ウズラクイズ
飼育委員の子どもたちが学校のウズラの動画を放送で流しウズラの生態を紹介しました。あわせてウズラクイズを校内のあちこちに掲示しています。「ウーちゃん ズーちゃん ラーちゃんが産まれたのは2019年のいつでしょう?①夏②秋③冬」答えは①夏です。といったクイズです。昨年度はウズラとのふれあい週間があったのですが今年度はできないのでその分いろいろと工夫してくれています。
2月19日(金) 長縄を楽しむ
中休みに校庭で長縄を楽しむ子どもがたくさんいます。体育の時間やペア学年集会で長縄をしているのでその影響もあるのでしょう。嬉しそうにぴょんぴょん跳ねる子どもたちでした。
2月18日(木) 花の水やり
環境美化委員会が花壇の花の水やりボランティアを募集して中休みに水やりをしています。水やりをしながら「虹が出ている~」と大喜びの子どもたち。パンジーやストックなど寒さに強い花が冬枯れの景色に潤いを与えてくれています。委員会、ボランティアの皆さんありがとうございます。
2月17日(水) 薬物乱用防止教室(6年生)
学校薬剤師の先生を講師にお招きし6年生が「薬物乱用防止教室」を開きました。ちょっとだけなら、1回だけならという気持ちで薬物に手を出し、依存症に陥る危険をスライドを通してお話しいただきました。6年生は真剣な表情で聞いていました。ご家庭でもぜひお子さんと話し合ってみてください。
2月16日(火) 長縄集会(ペア学年交流)
ペア学年の5年生と3年生が長縄集会で交流しました。今年はコロナの影響で思うように交流ができませんでしたが最後に校庭で汗を流して交流しようと、5年生の実行委員が中心になって企画しました。運動不足を解消しつつ交流を深める子どもたちでした。

2月15日(月) 新1年生保護者説明会
来年度入学予定の1年生保護者説明会を行いました。例年ですと全体会で説明をするのですが緊急事態宣言が出されているため資料の受け取りと個別相談のみの会としました。雨の中おいでいただいた保護者、育友会の皆様、通訳の方ありがとうございました。入学を心待ちにしています。
2月10日(水) 吉田新田探検(4年生)
快晴の空の下、4年生が社会科の学習の一環で吉田新田の探検に出かけました。第1回目は日枝神社や堰神社、大岡川の分岐点などを巡りました。学校名の由来にもなっている吉田新田は、江戸時代に吉田勘兵衛の干拓事業によって開発されました。教科書にも載っている有名な工事で、幾多の失敗や困難を乗り越え11年かけて成功させました。「昔の人のこころざし 南吉田の名にうけて~ ♪」は校歌の3番の歌詞ですが4年生は勘兵衛の困難に負けない志を感じることができたでしょうか。



2月9日(火) ライトアップ企画(5年生)
5年生が体育館のベランダと窓を使ってライトアップ企画をしています。オリパラ推進校として本来ならオリンピック半年前イベントとして行いたかったのですが、緊急事態宣言も延長されたことからひっそりとブルーライト(医療従事者を応援する意図です)で照らしています。8日(月)~10日(水)の3日間 17時ごろ~18時ごろまで行っています。ライトは南区役所からお借りしました。学校の近所を通りかかったらご覧ください。
2月8日(月) 桑の葉のお礼(3年生)
カイコを育てるための桑の葉を地域の方が届けてくださったというトピックを7月に載せたのですが、そのお礼に子どもたちがお手紙を書いて持って行きました。「ありがとうございました。おかげでカイコが元気に育ちました。」など一人一人がカイコの絵入りで綴りました。本来ですと直接お届けするところですが、緊急事態宣言下なので担任が代行して声を伝えに行きました。本当にありがとうございました。
2月5日(金) 音楽集会(3年生)
3年生は毎年区の音楽会に出場し南公会堂のステージで歌や演奏を披露しています。今年はコロナの影響で残念ながら区音楽会は中止となりました。その代わりに各クラスで練習してきたリコーダー演奏をVTR撮影し放送音楽集会として全校に流しました。真剣に演奏する子どもたちの姿に拍手がわき起こっていました。
2月4日(木) 避難訓練
大きな地震が発生し、続いて給食室から火事が起きたという想定で避難訓練を行いました。阪神淡路大震災も東日本大震災も寒い時期の発災でしたので多くの火事が起きています。地震の揺れからは身を守れても火災で命を落とすこともあります。「揺れを感じたら火の始末」をいつも心がけたいものです。子どもたちは「お」「か」「し」「も」を守ってしっかりと避難行動がとれました。
2月3日(水) アイマスク体験(4年生)
4年生は12月のボッチャ体験をもとに障害のある人たちへの理解を深めようと活動しています。今回は目の不自由な方への理解を深めるためにアイマスクをしてペアの子と階段を歩く体験をしました。活動の振り返りでは「ペアの子が『段差があるよ』『右に曲がるよ』などと言ってくれたので目が見えない人に伝えるのが助けになると思いました。」「周りの人が『階段がありますよ』とか『壁がありますよ』とか声をかけたり、支えてあげると安心すると思いました。」などと書いていました。こうした体験を通して、目の不自由な方の立場になって考えたり、声をかけたりできるようになるとよいですね。
2月2日(火) 節分
今日の給食は節分にちなんで揚げ大豆と煮魚(イワシ)に豚汁の和食メニューでした。豆は年の数だけ食べると健康に過ごせると言われています。1年の健康と安寧を祈念したいです。
学校の図書館には鬼の飾りと鬼のお話が並んでいます。「泣いた赤鬼」は不朽の名作ですね。
2月1日(月) 表彰
朝会で区巡回作品展 読書感想文コンクール 読書感想画コンクールに出品した児童を表彰しました。写真の児童は代表児童です。各学年に多彩な才能を発揮している子どもたちがいます。みんな得意な分野で活躍してほしいです。
1月28日(木) クラブ活動
学校では4年生以上の児童が参加してクラブ活動を行っています。子どもたちの希望に基づいて今年度は12のクラブが活動しています。1月から2月にかけては、例年3年生のクラブ見学やクラブ発表に向けての取組などで活動が盛り上がります。今年はコロナの影響で活動回数がいつもより少ないのですが、それでも発表会向けのVTR撮りを前に熱心に練習に励む子どもたちです。
今年のクラブ
外スポーツ、中スポーツ、卓球、陸上、ダンスバトン、パソコン、科学、バラエティゲーム、音楽、日本文化、手芸、図工マンガイラスト
1月27日(水) あいさつ運動
1月27日(水)~2月12日(金)まであいさつ運動を行います。今朝は運営委員が校門で登校する子どもたちを出迎えました。「おはようございます」「Good morning」「早上好」いろいろな国の言葉であいさつを交わします。その他にも教室にポスターを配付したり、階段に世界の言葉で「おはよう」「さようなら」を掲示したりします。この取組をきっかけにいつでも気持ちのよいあいさつが交わせるようになるとよいですね。
1月25日(月) 体力アップ
この時期、体育ではなわとびや持久走に取り組んでいます。コロナ禍で自粛生活が続き体力が落ちているので子どもたちはすぐに息が上がり「ハァハァ…」。けれども自分のペースで一定時間走ることを繰り返していると、息は上がりにくくなります。休み時間には体育委員会が配布した体力アップカードを手に竹馬やフラフープにもチャレンジしています。体力アップでカゼやウイルスに負けない体にしましょう。
1月22日 (金) 代表委員会
昨日の代表委員会は6年生ありがとうの会の計画を話し合いました。毎年この議題から5年生の運営委員や代表委員が中心となって話し合いを進めるようになります。5年生は最高額年として学校を引っ張る準備に入り、6年生は卒業に向けた動きを加速させていきます。6年生から5年生にしっかりとバトンを引き継いでほしいと思います。
1月21日(木) カイコその後(3年生)
卵からカイコを飼育してマユの状態で冷凍保存していた3年生が、学習のまとめとしてマユの作品作りに取り組んでいます。かわいらしいウサギやペンギン、キャラクターを器用に作っています。中にはお守りを作る子も。11月にはシルク博物館に行き養蚕について学習を深めてきた子どもたち。カイコ博士になれたかな?

1月19日(火) 給食週間
1月18日(月)~22日(金)の 1 週間は「学校給食週間」です。学校給食について改めて知る週間です。給食委員会を中心に様々な取り組みを行います。18日には児童集会で給食委員の子どもたちが給食かるたの作成を呼びかけ給食や食に関するクイズを出しました。「調理員さんの勤務時間は?」「鳥の卵で一番大きいのは?」「ミツバチが一生に集める蜂蜜の量は?」などなどちょっと難しい問題も。教室の子どもたちは頭をひねっていました。
給食週間なので普段は見られない給食室の様子を紹介します。
子どもたちに安全で安心な給食を提供するために細心の注意を払って仕事をしています。
できあがった献立と調理スタッフです。あらためておいしい給食に感謝していただきます。
1月18日(月) MY算数検定
今日は算数検定日。教室で検定に真剣に取り組む子どもたちです。1級がとれるまで頑張れ!
1月15日(金) クイズ集会
今朝は集会委員会のクイズ集会からスタートです。すっかりおなじみになったテレビ集会です。「氷を一瞬で溶かすにはどうすればいいでしょう」答えは「氷」の点を取るというとんち系クイズ。「空にあって毎晩少しずつ痩せたり太ったりするものはなんでしょう」答えは「月」(満月や三日月になるから)という科学系クイズ。「あるのに ないよ といわれるくだものは何だ」答えは「なし」というだじゃれ系クイズ。各種問題を取りそろえて朝から盛り上げてくれる子どもたちです。
1月14日(木) ユニセフ募金
ボランティア委員会の子どもたちが1月13日~14日の2日間ユニセフ募金を行いました。冬休み明けなので「お年玉から募金に回したよ」という子や「お家の人と相談してもって来たよ」という子も。集まった募金はユニセフ(国連児童基金)を通して世界中の支援の届きにくい子どもたちを守る活動に使われます。ご協力いただきありがとうございました。
1月13日(水) オリンピアン・パラリンピアン学校訪問事業(5・6年生)
学校訪問事業は、オリンピックやパラリンピックに出場した選手に直接話を聞いたり触れ合ったりすることで、スポーツのすばらしさや夢をもって努力することの大切さ、オリパラの魅力を知り、さらにスポーツを楽しもうとする姿勢を育てることを目的に行われている事業です。本校には北京オリンピック体操団体で銀メダルを獲得した中瀬卓也氏が来てくれました。始めに北京オリンピックのDVDを視聴した子どもたちは、その後困難を乗り越えて代表選手になるまでのお話に聞き入っていました。「夢を叶えるためには、他人と同じことをしていてはダメ」「簡単に諦めない」「愛される人になるためには、当たり前のことをできるようにすること」というお話は子どもたちの生き方を考える上でも示唆に富むものでした。講演後には実技指導をしてくださいました。中瀬選手の模範演技を見て、前転や後転を頑張る子どもたちでした。中瀬選手ありがとうございました。
1月8日(金)書き初め
各学年で書き初めを行っています。高学年は体育館で箏のBGMを聞きながら条幅に大きく力強い字を書いています。低学年は教室で名前ペンを使って丁寧に書いています。できた作品は教室や廊下に貼り出して互いに鑑賞します。みんななかなかよい字が書けています。
1月7日(木) MY漢字検定
休み明け恒例の漢字検定を行いました。冬休みに学習した成果を試すべく検定用紙に向かう子どもたちです。
全問正解できなかった子は再チャレンジでパーフェクトを目指します。粘り強く学習に取り組んでいます。
1月6日(水) 学校が始まりました
11日間の冬休みが終わり学校が始まりました。「明けましておめでとうございます。今年もよろしくお願いします。」と丁寧に挨拶をしてくれる子どもたちです。教室では「新年の目標」を考えているクラスもありました。「勉強を頑張りたい」「宿題を必ず提出したい」「友だちに優しくしたい」などの目標に混じって「コロナに負けない体力をつける」といっためあてを書いている子も。こんなところにもコロナの影響がでています。1日も早い収束を祈っています。
1月5日(火) 明日から学校です
新しい年が明けました。本年もどうぞよろしくお願いいたします。
緊急事態宣言が出されることになりそうですが、学校は感染予防を徹底し通常通り再開します。
12月25日(金) お楽しみ会&大掃除
冬休み前最後の日の今日は、お楽しみ会をしたり、休み中の課題を確認したり、大掃除をしたりと忙しい一日でした。百人一首大会で盛り上がるクラスも。サンタがやってきたクラスがあったとかなかったとか?1年の汚れを落とすべく隅々まで念入りに掃除する子どもたちです。今年も学校の教育活動にご協力いただきありがとうございました。皆様よいお年をお迎えください。
12月23日(水) 「ねらって ねらって」(1年生)
冬晴れの空の下で1年生が体育の時間にボール投げゲームを楽しんでいます。はじめはうまく投げられなかった子どもたちですが、的当てゲームに熱中して「何とか当てたいな」と粘り強く取り組んだ結果、うまく的に当てられるようになりました。ボール操作の技能を高めるとともに遊びの規則を守ったり、点を取る方法を工夫したり、チームで仲良く運動したり、安全に気をつけたりすることを遊びを通して学んでいきます。冬至の季節は陰が長く伸びています。
12月22日(火) ふわふわ言葉週間終わる
月曜日の児童朝会でふわふわ言葉週間でたくさんの言葉を考えてくれたクラスにメダルが渡されました。「がんばったね」「ありがとう」「よかったね」など素敵な言葉を考えてくれたみなさんありがとうございました。
12月21日(月) ロイロノート
横浜市では株式会社Loiloと連携協定を結びオンラインによる双方向での学習ができるように準備を進めています。本格運用は一人一台のPCが整備される令和3年度となりますが、学校では12月以降準備を整え欠席連絡やプリント配付などを試験的に運用していきたいと考えています。学校から配付されるプリントをご覧いただき接続確認等にご協力いただきますようお願いいたします。5年生がipadで実際にロイロノート体験をしました。自分の書いたデジタル付箋を送信しみんなで画面を確かめながら「こんなことができるんだ~」と驚きの表情です。子どもたちはどんどん操作方法を習得していくので、職員も負けじと研修会を開いて操作を覚えていきます。近い将来、学習風景が一変しているかもしれません!
12月18日(金) 人権集会
1時間目に人権集会を行いました。低学年はロブ・ルイス作 まつかわまゆみ訳 「ともだち」(評論社)という絵本の読み聞かせ後に教室で話し合ったり振り返りを書いたりしました。高学年はスライドを見た後でイソップ童話を聞き、「人権」について考えました。6年生の書いた振り返りです。「自分にとっては遊んでいるつもりでも相手を傷つけてしまっている場合があるから視点を変えて物事を見るべきだと思った」「気づかないうちに、悪気はなかった、そんなつもりはなかった と自分は思っていたとしても相手はどうかな?と考えなければいけない」「安心して笑顔で生活するために人の気持ちを考えて悪口を言わないようにしたい」「他人の気持ちを考えることは難しいけどよく考えないといけないことも多くあると思った」常に相手を思う気持ちを忘れないでいてください。
12月17日(木) 「ウー」ちゃん「ズー」ちゃん「ラー」ちゃん
学校ではウズラを3羽飼っています。名前を「ウー」ちゃん「ズー」ちゃん「ラー」ちゃんといいます。職員来客用の玄関ホールで飼っており飼育委員の子どもたちがお世話してくれています。1年生が国語の学習でそのウズラについてお家の人に伝える作文を書いています。ウズラを実際に観察しながら、頭は、足は、羽は、お腹はと詳しく書くための材料を集め文章の構成を考えていきます。なかなかよい作文に仕上がっています。嬉しいニュースです!昨年の1年生が書いたウズラの作文が「文集よこはま」に入選しました。生き生きとした作文で「ウー」ちゃん「ズー」ちゃん「ラー」ちゃんの様子がとてもよく伝わってきます。将来は作家さんかな?
12月15日(火) 寒波襲来
この冬一番の寒気が日本列島を覆い日本海側を中心に大雪になっています。寒さに震えながら登校した子どもたちも中休みには元気いっぱいに外遊びです。中には半袖で飛び回る子も。子どもは風の子とはよく言ったものです。抜けるような青空の下で仲良く遊ぶ子どもたちです。
12月11日(金) ボッチャ体験会(4年生)
この日は区役所地域振興課の職員の方にお願いし「ボッチャ体験会」を開催していただきました。ボッチャはパラリンピックの正式種目で老若男女、障害のあるなしに関わらず、誰でもできるスポーツです。ジャックボールと呼ばれる白いボール(目標球)に赤と青のボールをいかに近づけるかを競う競技です。はじめは戸惑っていた子どもたちでしたが、慣れてくると絶妙の位置に玉を転がす子も。チーム同士でよい競技会ができました。協力いただいた地域振興課の皆様ありがとうございました。
12月3日(木) 南消防署見学(3年生)
3年生が社会科学習の一環で南消防署見学に行きました。消防の仕事のDVDを見た後、消防車の装備見学、乗車体験、トレーニング場見学などとても丁寧に見学させていただきました。特に消防車の装備には質問が集中したくさんのメモがとれました。消防署の皆様ありがとうございました。将来消防士や消防団員を目指す子がでてくるとよいのですが・・・。
12月2日(水) 区巡回図工展
区巡回図工展が始まりました。中村小や石川小、日枝小など近隣校児童の優れた図工作品を各校で展示し鑑賞しあう毎年恒例の行事です。本校児童の作品も含め職員室前と玄関ホールに素敵な作品が展示してあります。子どもたちは作品を見上げて「じょうずだね」「すごいね」と話し合っています。12月16日(水)までです。
12月1日(火) 避難訓練
今日から12月、あと19日登校すると冬休みです。寒さも増してきましたが、中休みに地震想定の避難訓練を行いました。今回は休み時間に地震が発生したという設定で、校庭や教室、図書室など自分のいる場所で適切な避難行動をとれるようにすることが目的です。地震はいつ、どこで起きるかわかりません。状況に応じて命を守る行動がとれるように繰り返し訓練していきます。
11月30日(月) ふわふわ言葉週間
11月30日~12月11日までの2週間、広報掲示委員会が呼びかけてふわふわ言葉週間を全校で行います。というわけで校舎内のあちこちにクラスで書いてくれたハート型のふわふわ言葉が掲示されています。「ありがとう」「いっしょにやろう」「お疲れ様」など言われて心がふわふわする言葉です。中には「やればできる!」という力強い励ましの言葉も。12月はいじめ防止啓発月間でもあります。みんなで相手の気持ちを思いやる言葉がけができるように指導していきます。
11月24日(火) 非行防止教室(4年生)
「考えよう!やっていいこと 悪いこと」をテーマに4年生が非行防止教室を行いました。学校生活で起こりがちな場面をスライドで見ながら「いいこと 悪いこと」の区別をつけることの大切さを学びました。人を殴ったり、ものを壊したりすれば傷害罪や器物破損罪などの罪に問われることも学びました。「社会でダメなことは、学校でもダメ」という当たり前のことをしっかりと指導していきたいです。南警察スクールサポーターと南少年補導員のみなさんありがとうございました。
11月21日(土) 地域防災拠点訓練
大地震が起きた時などに備え、地域防災訓練が行われました。学校は防災拠点に指定されており、緊急時には一時避難場所として地域住民に利用していただけます。この日は寿東部地区町内会の皆様が、学校の門の鍵や体育館の鍵を確認したり、防災倉庫にある緊急連絡用電話を点検したりしました。災害は必ずやってくるので日頃からの準備が大切です。ご家庭でも災害時の約束事をぜひお子さんと確認しておいてください。
11月20日(金) 鎌倉修学旅行(6年生)
6年生が鎌倉に一日修学旅行に行きました。今年はコロナの影響で宿泊を伴う日光には行けませんでしたが、子どもたちは早くから実行委員会を立ち上げて、「心 歴史にきざもう 鎌倉修学旅行」を合い言葉に学習した鎌倉の歴史を新聞にまとめたり、しおりに書いたり、グループで回るコースを考えたりして当日を迎えました。鶴岡八幡宮、高徳院(大仏)、長谷寺、円覚寺、建長寺、万福寺などなど鎌倉の名所旧跡を訪ね秋の一日を楽しみました。ボランティアで付き添ってくださった皆さんありがとうございました。
帰校後には第二部を行いました。「疲れた」と言って帰ってきた割には、子どもたちはパワー全開で大爆笑の番外編を楽しみました。最後にはサプライズ企画も飛び出し、朝から晩まで学び・遊び尽くした一日でした。遅い時間にお迎えに来ていただいた保護者の皆様ありがとうございました。子どもたちの心に残ってくれれば嬉しいです。
11月17日(火) 八景島体験学習(5年生)
5年生が一日体験学習で八景島に行ってきました。水族館の大水槽で魚を見たり、イルカのショーを見たり、魚釣り体験をしたり、グループでランチをしたりと楽しい体験満載の一日でした。今回は行く場所の選択・決定から、行動計画まで子どもたちが中心となって活動をつくりあげていきました。コロナで宿泊はできませんでしたが、八景島も思い出に残る体験学習になりました。
11月16日(月) つながる国の遊び紹介
今朝は国際理解教室のエン先生から、マレーシアの子どもたちの遊びを動画で紹介していただきました。1つ目はシャトルコックを蹴り合う遊び、2つ目はホップスコッチという日本の「けんけんぱ」に似た遊びです。
南吉田小学校では毎年「友だちのつながる国の遊び」を取り上げて集会を開いています。今年はコロナ禍で実際に集まって遊ぶことができないので、放送での紹介となりました。国は違っても子どもの遊びには共通点がありますね。
11月13日(金) お絵かき集会
今朝は集会委員会の企画で大爆笑のお絵かき集会からスタートです。リレー形式で1枚の絵を完成させるのですが、制限時間は1人4秒、全体で5分間。次々と描き手が交代してできあがった絵を放送室でみんなにお披露目です。低学年と6組はドラえもん、中学年はプーさん、高学年は鬼滅の刃の炭次郎。なかなか上手に描けています。
11月11日(水) 2年生根岸森林公園遠足
昨年度よりも一回り成長した2年生、往路は速いペースで歩き、予定より20分も早く公園に到着しました。ウォークラリーでは、グループの友達と一緒にチェックポイントを回り、協力して課題を解決していました。昼食は、ソーシャルディスタンスを確保しながら、美味しそうに食べていました。午後もたっぷりと体を動かして遊び、復路もしっかりと歩いて無事に学校に到着しました。
11月10日(火) 就学時健康診断
来年度の1年生の健康診断を行いました。初めて来る学校に緊張した面持ちの子、リラックスして楽しげな子、兄姉と一緒に通うことを楽しみにしている子も。優しいお兄さんお姉さんがみなさんを待っていますよ。入学式までにはコロナが収まっていてほしいです。
11月9日(月) 児童朝会
11月は読書週間があります。児童朝会では図書委員の子どもたちがおすすめの本のクイズを出して「読書のすすめ」です。今年はコロナの影響で楽しみにしている朝の読み聞かせがありませんが、この機会に多くの本に親しんでほしいです。
11月6日(金) はまっ子交通安全教室
1年生と3年生が交通安全教室に参加しました。1年生は交通ルールの確認をしてから実際に道路を歩く練習です。3年生は自転車に乗って道路を走るときに気をつけることを実地で学びました。誰一人事故に遭うことなく安全に過ごせるとよいですね。季節がすすみ暗くなるのが早くなってきました。ぜひご家庭でも交通安全についてお子さんと話し合ってみてください。南警察署、南交通安全協会、区役所地域振興課の皆様ありがとうございました。また協力いただいた保護者、育友会の皆様ありがとうございました。
11月5日(木) 運動会その後
中休みに応援団の解散式が行われました。団長を中心にみんなでまとまって練習し全校を盛り上げてくれた子どもたちが、ここまでの振り返りをして来年につなぐための会です。団長からみんなへ労いの言葉がかけられて、頑張ったことを讃え合いました。中には終わってしまう悲しさに涙を流す子も。一生懸命に駆け抜けた子どもたちはとてもすがすがしい表情でした。6年生のみなさんお疲れ様でした。そして感動をありがとう。
応援団の担当から子どもたちに手渡された修了証
11月4日(水) リモート読み聞かせ
運動会の余韻を感じながら登校した子どもたち、今朝は読み聞かせからのスタートです。例年ですとボランティアの皆さんが各クラスを回って直に読み聞かせをしてくださるのですが、今年はコロナの影響でできていませんでした。ならばリモートで!ということで本日テレビ放送で読み聞かせをしてくださいました。タイトルは「オニのサラリーマン」(福音館書店)です。読み手の保護者の方は子どもたちに伝わりやすいようにと事前に何度も練習して今日を迎えたとのこと。本当にありがとうございます。久しぶりの読み聞かせ放送を子どもたちは食い入るように見ていました。
10月31日(土) MYキッズスポーツフェスティバル
爽やかな秋空の下でMYキッズスポーツフェスティバル2020(運動会)を開催しました。コロナの影響で保護者の参加人数を制限し、短縮バージョンでの開催でしたが、多くの保護者の方に参観いただきありがとうございました。育友会の皆様、おやじたちの会の皆様ご協力ありがとうございました。コロナに負けずに頑張るMYキッズの姿はいかがでしたでしょうか。制約のある中でも精一杯頑張った子どもたちに大きな拍手を送りたいです。
10月30日(金) 白虎と朱雀
今日の給食は運動会スペシャルバージョンです。運動会の白組紅組のキャラクターである白虎と朱雀を型抜きしたにんじんがチリコンカーンの上で踊っています。給食でも運動会の機運を盛り上げています。
10月29日(木) 運動会の学び
「キレキレの演技ですごいと思いました。」「1年生から5年生は演技ができないので、私たちの思いもこめて当日は踊ってください。」これは6年生が運動会で踊るソーラン節を見学した5年生の感想です。1~5年は競技と徒競走しかできませんが、6年生だけは小学校生活の最後を飾る演技ができます。今日はこれまでの練習の成果を5年生に披露し、本番に向けて気合を入れる時間でした。これまでも6年生は一生懸命に練習してきたのですが、5年生に見られているとあって今日は真剣そのものです。ギアが1段上がった感じの演技でした。「当日はもっとすごい踊りを見せてくれることを期待しています。」との5年生の言葉に「やるしかない。」と気合を入れなおした6年生でした。こうした経験を積み重ねて子どもたちは一歩また一歩と成長していきます。
10月27日(火) 運動会全体練習
26日(月)から3日間運動会の全体練習が行われています。今年は開閉会式と応援だけ全体で行うので全体練習もシンプルです。実行委員の子どもたちの準備は順調です。司会や壇上で話す子どもたちは、「緊張する!」と言いつつ自分の言葉でよどみなく話すことができます。応援団も役割を自覚し、しっかり全校を盛り上げてくれています。コロナ禍ではありますが、子どもたちの頑張りが光る運動会練習です。
10月26日(月) 稲刈り 5年生
学校再開後すぐの6月4日に5年生が学校田んぼに植えた稲が実り稲刈りをしました。今年は暑かったのとせっせとお世話をしたので、すくすくと育ちたくさんのお米が獲れそうです。
5月の田んぼの様子。
6月の田んぼの様子。
10月の田んぼの様子。「農家の人みたい」
10月23日(金) トイレが新しくなりました
7月から改修していた西側トイレの工事が終わり、今日から使えるようになりました。明るくてピカピカのトイレになりました。子どもたちに感想を聞いてみると「明るくてきれい」「個室が広くなった」と好評です。みんなできれいに使っていきたいです。
10月22日(木) 野毛山動物園遠足 1年生
秋晴れの下、1年生が野毛山動物園まで歩いて遠足に行きました。往きは元気いっぱいで速いペースで歩き、あっという間に動物園に着きました。動物園では、はじめにクラスのみんなで園内を一周した後、グループ毎に見学しました。ライオンの大きな鳴き声にびっくりしながら、班の友達と協力して見学をしていました。昼食後は夢中になってドングリ拾いを行い、自然とたっぷりふれ合いました。復路はくたくたに疲れていましたが、学校まで安全に歩くことができました。
10月20日(火) 応援団
応援団の練習が熱を帯びてきました。連日中休みに体育館に集まって団長の指示の下練習に励んでいます。今年はコロナの影響で全員が声をそろえての大応援はできません。せめて応援団だけでも元気よく応援して運動会を盛り上げるべく知恵を絞っています。どんな応援になるかご期待ください。
10月19日(月) 運動会集会
運動会に向けて職員室前廊下ではカウントダウンが始まっています。今日は運動会集会で中学年の競技の紹介をしてくれました。中学年は「落とさず運ぼう!開店!回転!MYバーガー」という密を避けるための新競技を考案です。詳細はお楽しみに。
10月15日(木) 根岸森林公園遠足は延期になりましたが・・
2年生が楽しみにしていた遠足は残念ながら雨のため延期になってしまいました。意気消沈する子どもたちでしたが5時間目に学年のお楽しみ集会があると聞いて復活です。体育館で思い切り体を動かしてじゃんけんゲームやダンス、鬼ごっこをして楽しみました。次回は晴れるとよいですね。
10月14日(水) 後期が始まりました
月曜日に期分式を行い火曜日から後期が始まりました。期分式で6年生がこんな作文を読んでくれました。「後期は運動会だけでなく、遠足や体験学習、修学旅行があります。6年の修学旅行は今年だからこそできることをみんなで考えて楽しみながらやっていけたらいいなと思います。他の学年のみなさんもきっと同じ思いですよね。世の中で悲しいことがたくさんあっても、友だちと助け合いながら、みんなで楽しい学校生活にしていきたいです。」コロナ禍ではありますが後期も感染予防に留意して今だからこそできることを考えていきたいです。
10月9日(金) 愛川体験学習 4年生
4年生が楽しみにしていた愛川体験学習に出かけました。雨の中での実施となりましたがいろいろな体験ができました。宮ヶ瀬ダムは台風に備えて?導水管から大量の水を放流しており子どもたちは「すごい!」を連発。大迫力の光景を見学しました。レインボープラザでの藍染体験では思い思いの模様に染め上がり「お~」と感激。手も藍色に染まりました。そして愛川ふれあいの村のキャンドルファイヤーでは実行委員の子どもたちが上手に会を運営し楽しい一時を過ごしました。宿泊はできませんでしたがたくさんのことを学んだ体験学習でした。遅い時間にお迎えにきていただいた保護者の皆様本当にありがとうございました。
出発式では2年生がお見送りに来てくれました。
10月8日(木) 野毛山動物園遠足延期
1年生が楽しみにしていた野毛山動物園への遠足が雨のため延期になってしまいました。台風で秋雨前線が活発化し関東地方に雨を降らせている模様です。せっかく作ったてるてる坊主が心なしか寂しそうに見えます。延期は残念ですが楽しいこともあるようです。お昼の時間をのぞいてみると、「タコウインナーだよ」「梅干し大好き~」「パンダのおにぎり」などとお弁当の中身を説明してくれます。大好きなおかずに笑顔が広がる1年生です。
10月5日(月) 運動会月間はじまり
MYキッズスポーツフェスティバル(運動会)が迫ってきました。今年は新型コロナウイルス感染症の影響でいつもとは大幅に違うプログラムでの開催です。今日の朝会で運動会の話をしました。スローガンが決まり、マスコットも決まり、応援団長も今週には決定します。いつも通りではありませんがこんな時期だからこそみんなのアイデアと工夫で盛り上げたいと思います。
10月2日(金) 大じゃんけん大会&シャボン玉遊び交流
今朝の集会は「目指せ!テレビ出演 学校一を決めよう 大じゃんけん大会」という長い名前の集会でした。テレビで集会委員とじゃんけんをしてクラス代表を決め、廊下で学年代表を決める勝負をします。そして学年代表が放送室に集合してインタビューを受けた後で学校一を決める勝負をするという企画です。密を避けるためのアイデアですが放送集会もなかなかの人気です。
集会の後には1年と6年のペア学年が校庭でシャボン玉遊びをして交流しました。優しいお兄さんお姉さんと一緒に遊べて1年生は大喜びでした。
9月30日(水) 心の教育ふれあいコンサート
オーケストラによる生の演奏を聴き心豊かなひとときを過ごすとともに、音楽鑑賞のマナーやルールを学ぶ目的で5年生が「心の教育ふれあいコンサート」に参加しました。初めて見るみなとみらいホールに目を丸くする子や独特の雰囲気に「緊張するな」とつぶやく子もいました。一流のホールで聴くオーケストラの演奏に心から拍手を送る子どもたちでした。
コンサートの後は近くのオービィ横浜に出かけました。都会の真ん中でネイチャー体験ができ50種類の動物と触れ合える施設です。ネコやウサギ、モルモット、ヒヨコ、カピバラにハリネズミなどと実際に触れ合い大喜びでした。
9月28日(月) 運動会のスローガン
児童朝会で先日の代表委員会で決まった今年の運動会のスローガン発表がありました。体育委員会の委員長さんたちが緊張した面持ちで放送室からテレビカメラに向けて発表します。コンセプトは3つのあいで「助け合い 支え合い たたえ合い」に決まりました。コロナ禍の運動会ですがスローガンの通りの3つのあいが生まれることを期待しています。
9月24日(木) 歴史の授業
6年生が歴史の授業で土嚢積みの体験をしました。鎌倉時代、元の来襲に備えるために博多湾岸に20kmにわたって築かれた「元寇防塁」について体験を通して理解を深めることが目的です。機械などない時代に手作業で築いた防塁に思いをはせる子どもたちです。どんな感想をもったかきいてみたいです。
9月23日(水) 体育館床張り換え完了
夏休み前から工事していた体育館の床の張り替え工事が完了し今日から使用できるようになりました。今日は5年生が横浜市スポーツ協会の出前授業「ゆるスポーツ体験」でピカピカの体育館の使い初めです。床面が文字通りピカピカで光り輝いていました。「ゆるスポーツ」は誰でも楽しく参加できる新しいタイプのスポーツでインストラクターの指導の下で笑顔があふれていました。
9月18日(金) デジタル教材
学校ではICTを活用した授業に積極的に取り組んでいます。教室では算数や英語のデジタル教科書が大活躍しています。3年生の図工ではipadで取り込んだ自分の写真を加工した作品づくりに励んでいます。3枚目の写真は恒例になったZoom代表委員会です。国の施策である「GIGAスクール構想」が前倒しになり今年度中には児童1人に1台のPC(ipad)が配当され、学校に高速大容量の通信ネットワークが整備される予定です。
9月16日(水) MY検定の表彰
月曜日の朝会で夏休み後に取り組んだMY検定の賞状を6年生の代表児童に渡しました。MY検定は夏休みの家庭学習で高まった「ひらがな・漢字」や「算数」の力を試すことを目的に実施している全校一斉の活動です。授業時間に実施するのはそれぞれ1回ずつですが、休み時間等を利用して再チャレンジが可能です。1回目の検定で満点(50点)をとれた子どもには王冠シールがプレゼントされます。MY検定で子どもたちの力が伸びることを期待します。
9月14日(月) アイディア募集中
9月の代表委員会の議題は「MYスポのスローガンを決めよう」です。10月31日に行う予定の運動会はコロナの影響でいつもと違いますが学校全体で力を合わせて楽しく悔いのない運動会にするためのスローガンを考えてほしいとのことです。同じく飼育委員会がMYスポのマスコットを募集中です。広報掲示委員会は壁新聞に取り上げてほしい記事の内容を募集しています。こちらも運動会関係の記事が中心でしょうか。1ヶ月半後に迫った運動会に向けて子どもたちと一緒に活動をつくっています。
9月10日(木) シャボン玉遊び
1年生が生活科の学習で季節の遊びを楽しんでいます。今日は少しだけ涼しくなった校庭でシャボン玉を飛ばしました。ストロー、ラップの芯、ペットボトル、モールなどの素材に手を加え工夫をこらした特性装置を作り、シャボン玉飛ばしを楽しんでいました。
9月9日(水) 卒業アルバム用写真
6年生が卒業アルバムの個人写真を撮影しました。学校が再開してまだあまりたっていないのですが、もう卒業に向けた取組が始まっています。子どもたちは「緊張するな~」と言いつつよい笑顔で写真に収まっていました。今年のアルバムはどんな風に仕上がるのか楽しみです。

9月8日(火) まだまだ暑いので・・
9月も中旬になろうというのに、日中はまだまだ暑い日が続いています。子どもたちに人気なのが玄関に置かれる氷の塊です。冷凍庫で凍らせて暑い日に時々予告なしで出現します。中に向日葵(造花)を入れて彩りを添えています。涼しくなるまでにあと何回見られるでしょうか。
9月3日(木) あったらいいなこんなもの(2年生)
2年生が国語の時間に考えた「あったらいいなこんなもの」の発表会を行いました。クラスで発表練習をして本番ではクラスをシャッフルして、4組+国際教室の5クラスで発表を行いました。子どもたちは発表を真剣に聞き合い質問や感想のやりとりをしていました。忘れものが出てくるカバンはぜひ開発してほしいですね。
9月1日(火) ベイスターズ青星寮カレー
今日の給食は横浜DeNAベイスターズのファームチーム施設「青星寮」(選手寮)の食堂で出されている定番メニューの「青星寮カレー」とごまずあえ、プルーン発酵乳でした。「お肉と野菜で栄養満点、みなさん残さず食べましょう」という今永選手のメッセージ付きで、子どもたちは残さず食べていました。
8月31日(月) 熱中症予防
明日から9月だというのに猛暑の日が続いています。今日は校庭の日向に設置した温度計が39度を示し、熱中症の危険があることから午後の屋外での活動は休止となりました。こんな時は放送でお知らせをするのですが、はじめのうちは教室からえ~という声が聞こえてきました。けれどもこう連日暑いと子どもも慣れてきて、冷房の効いた室内での遊びを工夫しています。もう少しで涼しくなると信じて、校庭の温度計とにらめっこする日々です。
8月21日(金) トイレ・体育館改修その後
7月に始まった西側トイレの改築と体育館の床の張り替え工事が順調に進んでいます。トイレは便器や壁が取り払われてコンクリートがむき出しの状態です。体育館の床はすでに張り替えがほぼ完了し、この後塗装します。工事の期間中、ご不便をおかけしますが、きれいなトイレやピカピカの体育館が完成するのを心待ちにしたいです。猛暑の中で作業をしてくださる業者の皆さんにも感謝です。
8月19日(水) リモート学年集会?
6年生がZOOMを活用したリモート学年集会「第1回ロッククライミングカップ」を行いました。各クラスでカードゲーム選手権を行い勝ち残った代表者が別室で決勝戦をします。その様子をクラスでネット中継しオンラインで盛り上がりました。みんなで一カ所に集まって楽しむことができない分、ネットを活用して一体感をだすアイデアは新しい生活様式ならぬ新しい学習様式?でしょうか。
8月18日(火) 夏休み明け
16日間の夏休みを終えて学校が始まりました。連日の猛暑で子どもたちは汗を流しながら学習に励んでいます。エアコンはフル稼働ですが、外が暑すぎてなかなか冷えません。何とか早くこの暑さが収まってくれることを願うばかりです。8月中は子どもたちの健康と安全を最優先に過ごしていきます。
校庭ではヒマワリが太陽に向かって元気よく咲いています。個別支援級の子どもたちが育てている枝豆や5年生の育てる稲もすくすくと大きくなっています。
7月31日(金) 前期前半終了
6月から再開した学校は43日間の授業を終えて夏休みを迎えます。子どもたちは図工の作品や虫かごを大事そうに抱えて嬉しそうに「さようなら」「またね」と言いながら帰って行きました。今年はコロナウイルスの影響で夏休みが2週間しかありませんが、心も体も一息ついて8月からの授業に備えてほしいと思います。生活リズムを崩さないように2週間を過ごせるとよいですね。
7月30日(木) インターネットの使い方(6年)
6年生がインターネットにからむトラブル、いじめ、依存症などについて学びました。総務省が発行しているインターネットトラブル事例集を活用し、身近に潜む危険について理解を深めました。担任がラインでありがちなトラブルを実演し、「これっていいのかな?」と考えさせる場面も。夏休みはネットに絡むトラブルが増加する時期です。ご家庭でも今一度インターネットの使い方について話題にしてみてください。
7月29日(水) 生活・学校ガイダンス
最近来日した外国人保護者や新1年生の外国人保護者向けの生活・学校ガイダンスを開催しました。学校、みなみ市民活動・多文化共生ラウンジ、南区役所、資源循環局が共同で実施し、南区の「生活のしおり」の説明、ゴミの分別の仕方、学校生活の話、日本語学習のことなどを3カ国語の通訳を入れて説明しました。参加された保護者の方々はみな熱心に聞き質問がたくさん出されました。
7月28日(火) 学年集会(5年生)
5年生が学年ドッジボール大会を開催しました。子どもたちの発案で行ったイベントで汗を流しながら楽しい一時を過ごしました。次回の学年集会も楽しみです。
7月27日(月) 夏休み前 最終週
例年ですとすでに夏休みに入っていますが今年は新型コロナウイルスの影響で7月いっぱい授業があります。日が出たり急な雨が降ったりと変わりやすい天気の中、1年生が校庭で夏の遊びを楽しみました。今年は水泳学習ができないので残念ですがせめて水遊びで夏らしさを味わってほしいです。
7月22日(水) 委員会活動
高学年児童の委員会活動が本格化しています。ボランティア委員会の子どもたちは昇降口の傘立てをきれいに整えてくれています。環境美化委員会は花壇の雑草取り、広報掲示委員会は校内新聞の発行、放送委員は朝やお昼の校内放送・・・とみんな頑張っています。「笑顔で結びつなげよう南吉田」のスローガンに近づくためにいろいろな場面で活躍する5・6年生児童です。
7月20日(月) 外国語活動・外国語
学習指導要領が改訂され今年から全国的に外国語(英語)を学ぶ時間が入りました。3・4年生35時間、5・6年生70時間が正式に位置づけられ教科書を用いての学習となります。担任と外国人のアシスタントティーチャーとのコラボ授業もあり日常的にネイティブイングリッシュにふれる機会を設けています。
7月17日(金) リモート代表委員会
16日(木)ZOOMを利用して代表委員会を開きました。いつもなら教室で開くのですが、人数が多いので密を避けてオンラインで開催しました。今年の児童会のスローガン「笑顔で結びつなげよう南吉田」~キラキラスマイルとふわふわハートでつながろう!~の実現のためにクラスでできることや委員会で頑張ることを真剣に話し合いました。リモート代表委員会はいつもと違い新鮮な会議でした。
7月16日(木) 梅雨の晴れ間
雨模様の日が続きますが、今日は久しぶりに太陽が顔を出しました。休み時間には校庭を子どもたちが大喜びで駆け回っています。友だちと外で思い切り体を動かして遊んだ後は、授業にも集中できるようです。
7月15日(水) カブトムシ
保護者の方から立派なカブトムシをたくさんいただきました。学校周辺では身近に出会える生き物ではないので子どもたちは大興奮です。早速、家から飼育セットを持ってきた子どももおり飼う気満々です。卵を産んで来年につながるとよいですね。
7月13日(月) 委員長認定式
今年度の委員会活動が始まりました。今日は児童朝会(放送朝会)で各委員長の紹介と認定証の授与式を行いました。6年生は委員会の委員長やクラブの部長、登校班の班長などの役割を担うことで最高学年としての自覚と責任感を養います。下級生に憧れられるリーダーに育ってほしいと思います。

7月9日(木) カイコの飼育
3年生がカイコを育てています。卵から孵化させてマユになるまで育てるのですが、その間の成長を観察し記録にとっていきます。カイコは桑の葉を食べますが、学校の桑だけでは足りません。そこで地域の方が桑の葉を毎年持ってきてくださいます。新鮮な桑の葉を食べてカイコはすくすくと育っています。
7月8日(水) ポークカレー
今日の給食は今年初めてのポークカレーでした。子どもたちはカレーが大好き。給食室から漂ってくるカレーのよい香りにお腹がグーグー鳴っていた子もいたようです。ごまずあえ、はいがごはん、飲むヨーグルトどれも残さず食べられたかな。
7月7日(火) 七夕
七夕は昔中国から日本に伝わった星の祭りです。彦星と織姫という男女の星が、天の川をはさんで向かい合っていて、2つの星が1年に1度、7月7日にだけ会えるという言い伝えから祭りが始まりました。(21世紀こども百科 小学館) 学校のあちこちに七夕飾りが飾られています。短冊には「コロナが終わりますように」といった願い事が散見されます。一日も早い終息を願いたいです。
7月6日(月) 西側トイレ・体育館改修工事開始
7月4日から西側トイレと体育館の改修工事が始まりました。トイレ改修の前にまずピロティに仮設トイレが設置されます。4年・5年・6年は西側トイレが使えなくなるので、東側トイレと仮設トイレを使うことになります。また体育館の床面張り替え工事も同時に始まり、ピロティの反対側に仮囲いが設置されました。ピロティが狭くなってしまうので注意して通行したいです。完成が楽しみです。
7月4日(土) おやじたちの会 ミスト設置
おやじたちの会のお父さんたちが新校舎との間の渡り廊下にミストを取り付けてくれました。今年はプールができず、夏休みも短いのでせめて校庭でミストを浴びて涼んでほしいです。素敵なプレゼントにきっと子どもたちは大喜びでしょう。お父さんたちありがとうございました。
7月3日(金) 虫取り隊(2年生)
2年生が生活科の学習で虫取りを楽しんでいます。校庭の隅々まで探検し、小さな虫を次々発見していきます。ダンゴムシ、アリ、バッタ、カタツムリ、ナメクジ、蝶に蛾・・・街中の学校でもいろいろな種類の虫が見つかるものです。見つけた虫は教室で観察し、記録に残します。虫かごと虫取り網を持った小さな探検隊の歓声が校内に響いています。

7月2日(木) 6年生の学び
6年生が国語で「私と本」という学習に取り組んでいます。お気に入りの本を選んで原稿を書き友だちに紹介するという授業です。今日は実際に紹介するブックトークを行いました。トークはビデオ録画し振り返りに使われます。子どもたちは相手を意識して、わかりやすく伝えていました。
7月1日(水) 第3期通常登校
本日から第3期通常登校となります。「待ちに待った」給食の再開に子どもたちも大喜びでした。今日のメニューは豚汁、ツナそぼろ、ご飯、牛乳にクッキーもついての豪華版です。「おいしい!」「しあわせ」と小さい声でささやきながら給食を味わっていました。学校にいる時間が延びる分、疲れもたまりやすいので健康管理には引き続き注意をお願いします。
6月30日(火) 給食準備
明日からの給食に備えて1年生が練習をしました。まずは手洗い、次に白衣を着て、帽子をかぶり、給食用マスクをつけて準備完了。当番になる子どもたちは牛乳、食器、食管、ご飯など持ち物の確認も。「給食楽しみ!」と期待する声がたくさん聞こえてきました。
放課後は職員が新型コロナウイルス感染症予防を意識した新しい給食の配り方や食べ方を確認しました。まだグループで食べることができませんがしばらくの辛抱です。
6月26日(金) 1年生を迎える会
今日は2ヶ月遅れの1年生を迎える会がありました。といっても全校が体育館に集まることはまだできないので、校内テレビ放送を利用しての会です。昨年度児童運営委員だった6年生が計画し、各学年で南吉田小クイズを考えて、1年生に出題します。放送室前の廊下でドキドキしながら出番を待っている子どもたちは体育館の時と少し様子が違っています。テレビに映ることは思いのほか緊張するようです。カメラの前で立派に役目を果たした子どもたちは「ふ~緊張した」と放送室から出てきます。1年生は、お兄さんお姉さんの出してくれるクイズに元気に答えながら、楽しんでいました。今年は全校での集会はできませんが、工夫しながら盛り上がっていってくれることでしょう。運営委員のみなさんありがとうございました。
6月24日(水) 防犯教室(1年生)
登下校時や、放課後・休日などの外出時の声かけ事案や誘拐などの危険から身を守るために防犯教室を行いました。始めにDVDを視聴した後、パワーポイントによる説明をきき、最後に実際の場面を想定したロールプレイによる「断り方」「逃げ方」の実演を行いました。子どもたちは講師の話や演技に聞き入っていました。誰一人事件・事故に巻き込まれないことを願っています。神奈川県庁くらし安全交通課、南警察スクールサポーターの皆様、ご協力ありがとうございました。
6月22日(月) 一斉登校2週目
一斉登校が始まって2週目を迎えます。クラスの友だちと過ごす時間が増えてよかったと思っている子も多いようで、帰り際に「また明日ね」と名残惜しそうに別れていく場面を見かけます。雨の日が続き、エネルギーを持て余す子もおり、ケガのないように過ごせるように指導しています。昇降口の傘はきれいに整えられ、長靴も整然と靴箱に収まっています。整理整頓することで気持ちも整うとよいですね。
6月19日(金) 雨の日の過ごし方
梅雨に入り雨の日が増えてきました。6組の子どもたちが作った紫陽花のカレンダーが季節感を伝えてくれています。雨が降ると校庭に出られないので図書室が人気です。友だちと誘い合って本を読んだり、借りたりして楽しんでいます。大人気の図書室でも「密になっちゃうよ」と声をかけ合う子どもたちです。
6月17日(水) 地区登校班会議
6月15日から6月30日までは集団登校ですが、今日は地区別の登校班会議を行いました。放送の合図で6年生が1年生を迎えに行き、集合場所(教室や体育館)に連れて行きます。メンバーが集まったら、班長さんを中心に登校時の集合場所や集合時間を確認し、通学時の安全上の注意などを伝えました。1年間子どもたちが安全に登校してくれることを願っています。班長さん下級生が安全に登校できるようお願いします。
6月16日(火) 一斉登校2日目
一斉登校2日目。集団登校班の班長さんたちが下級生を気遣いながら引率してきてくれています。保護者・地域の皆様にも見守りをしていただきありがとうございます。今日は新年度初めての避難訓練を行いました。地震を想定しての訓練でしたが、子どもたちは真剣に参加していました。今年は自然災害から命を守るだけでなく、新型コロナウイルス感染症からも命を守る必要がありますが、気を抜くことなく緊張感をもって生活していきたいです。
6月15日(月) 短時間一斉登校
6月に学校が再開し分散登校を行ってきましたが、大きな混乱や学校でのクラスター感染などが発生しなかったことから、第2期として短時間一斉登校となります。今日からはクラスの全員が揃っての授業です。早速クラスみんなで知り合うゲームをしたり、学年の出発式を行ったり、クラスのめあてを話し合ったりして再出発を味わっていました。全員揃っても引き続き外遊びの後には手洗い励行です。
6月12日(金) 梅雨入り
関東地方が梅雨入りしました。校庭では紫陽花が見頃です。クチナシも負けじと花を咲かせています。4年生がヘチマと瓢箪を花壇に植え付けました。5年生が植えた稲はしっかり根付いています。トマトや朝顔も元気に育っています。雨の季節は人には鬱陶しいと思われがちですが、植物には歓迎されているようです。今週で分散登校が終了し15日(月)から一斉登校となりますが、引き続き3密を避けた生活の仕方を指導していきます。
6月11日(木) 学校探検&ヤゴの観察
1年生が学校のあちこちを探検しています。職員室にやってきたクラスの子どもたちは、職員室の入り方のルールを教えてもらい「1年○組 ○○です」とさっそく試していました。「今度、校長室に行ってもいいですか」と尋ねてくる子もいて、興味津々で活動を楽しんでいます。2年生はプールの掃除にあわせてとったヤゴを教室で育てています。成虫になって飛び立つ個体もあり、子どもたちは目をまん丸にしてヤゴやトンボに見入っています。
6月9日(火) 熱中症対策
感染症予防対策とともに熱中症予防対策が必要な時期になってきました。学校では市の熱中症対策ガイドラインにそって次のような指導を行っています。①こまめな水分補給②WBGT計による暑さ指数の計測③体育時など激しい運動を行うときのマスクの着脱などです。国から出されている熱中症予防のガイドでも体育時のマスクについては状況に応じて外しても構わないとされています。感染症予防を優先するあまり熱中症対で倒れることのないようにバランスを取っていきたいです。
WBGT計
6月8日(月) 分散登校2週目
分散登校2週目を迎えました。今週からABグループが入れ替わっての登校です。生活リズムをつくるのが大変ですがご協力をお願いします。1週間がたち学習も軌道に乗ってきました。学級では少人数のうちに生活や学習のルールを定着させ、全員が揃ったときにも困らないようにしています。お互いに学んだことを記録に残すことで刺激し合っているクラスもあります。
6月5日(金) クラスの仲間と知り合う工夫
分散登校中はクラスの全員が顔を合わせることができません。そこで自己紹介カードや、お互いの活動の写真を貼って紹介し合っています。来週はグループの登校時間が入れ替わるので生活のリズムが崩れないようにしたいですね。暑くなってきたので体調管理にお気をつけください。
6月4日(木) 体験的な学び
分散登校4日目。今日は5年生が田起をして稲を植える準備をしました。いつの間にか水に入っての作業?が心地よい季節となりました。泥に親しむ子どもたちの姿はとても微笑ましかったです。秋にはたわわに実ることを期待したいです。
6月3日(水) 少人数での学び
分散登校3日目。学習が本格的にスタートしています。いつもより人数が少ないので張り切って手を挙げて発言する子どもの姿も。短時間ですが、体を動かしたり、生き物や植物の観察をしたり、教科書を使って学んだりとメリハリをつけて学んでいます。「やっぱり学校はいいな」と思ってもらえるように工夫しながら進めています。
6月2日(火) 今日は開港記念日です
6月2日(火) よろこび爆発?
再開2日目の今日は、外で元気に体を動かす子どもたちの表情がとても明るく楽しそうでした。マスクをつけて、隣との距離も気にしての一時ですが、久しぶりに友だちとおしゃべりしたり、遊んだりなんだかとても幸せそうでした。もちろん、遊んだ後は「手洗い・うがい」を励行します。
6月1日(月) 学校再開
4月7日以来約2か月ぶりに学校が再開されました。子どもたちは久しぶりの学校を楽しみにしていた様子で、「久しぶりだね」「友達に会いたかったよ」と元気に話してくれました。分散登校期間は子ども同士の距離を離して座ったり、3密を避けたり、手洗い、うがい、マスクをしたりなど新しい生活の仕方に慣れていきます。学校のあちこちに貼紙をして子どもたちの意識を高めていきたいと思います。生活リズムを戻して毎日元気に登校してくれることを願っています。
5月29日(金)②
5月29(金)①
5月28日(木)③
5月28日(木)②


5月28日(木)①
5月27日(水)②
5月27日(水)①
5月26日(火)③
5月26日(火)②
5月26日(火)①
 日
日

5月25日(月)②
5月25日(月)①

5月22日(金)③
5月22日(金)②

5月22日(金)①


5月21日(木)②
5月21日(木)①
5月20日(水)②
5月20日(水)①
5月19日(火)
5月18日(月)③
5月18日(月)②

5月18日(月)①
5月15日(金)②
5月15日(金)①
5月14日(木)②
5月14日(木)①
5月11日(月)

5月5日

MY magazine発行
5月になりました
先が見えない毎日ですが、3密に気をつけながら学校再開に向けて準備を進めています。今日は古くなったマットを廃棄するために職員作業です。ベルマークで購入してもらった新しいマットが子どもたちを待っています!
令和2年度 入学式
桜の花びらが舞い散る中で、令和2年度入学式を行いました。今年は新型コロナウイルス感染症の影響で規模を縮小し、時間も短縮しての式でしたが、子どもたちにとっては待ちに待った入学式!?とても立派な態度で参加できました。今日からはピカピカの1年生、いろいろなことにチャレンジしてできることを増やしていきましょう。保護者の皆様、新入学おめでとうございます。